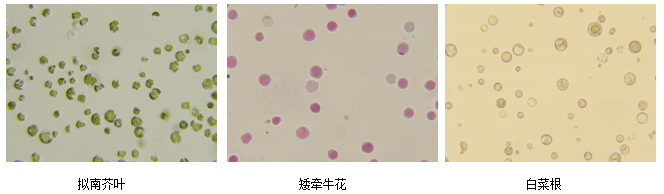

与高级生信分析面对面!单细胞分析不犯难!
与高级生信分析面对面!单细胞分析不犯难!
夏天到了,热浪席卷了大半个中国!时空组学火了,火苗蔓延到了生物行业的各个角落!生物公司铺天盖地的产品宣传、高校科研院所如鹅毛般的文章产出、实验室热闹非凡的技术交流,无不昭告着时空组学的大火!
大火之后就是普适化,但正如每个技术从诞生到成熟经历的一样,单细胞技术也在经历着从新技术到普适化转变的阵痛:浩繁庞杂的数据让普通科研工作者无所适从!种类繁多的高级分析让刚接触的老师无从选择!新检出的细胞群、差异基因让应用型研究人员不知从何用起!即使是懂分析、会代码的老师,也会面临一个问题:服务器资源不足!

单细胞转录组分析流程
搭建单细胞项目全流程沟通平台
考虑到以上问题,开泰在推单细胞多组学的过程中,也摸索出了一套完整流畅的单细胞产品运转流程:前期高级技术支持和老师沟通方案设计、采样、取样、送样细节(微信群+线上沟通);中期实验人员解离、提核积极反馈中间情况和最终结果,沟通上机(微信群+实时图片+电子版报告);后期配备一对一高级生信分析人员与老师群里、线上沟通,推进单细胞分析,直至发文!该套运转流程获得客户一致好评,用过的老师都说这样推进单细胞项目,顺畅多了!
与高级生信分析及时线上沟通,无惧高级分析内容
做过单细胞项目的老师应该都了解,单细胞项目分析并不是流程化的内容,需要老师的参与度很高,但老师仅仅是提供生物学背景和需求的一方,分析大部分还需要生信人员来完成。因此这期间的沟通需要非常频繁和专业,有些同行会在这个沟通中间安排销售和运营经理介入传达,美其名曰保护生信人员不受外界干扰,经历过的老师都知道,中间等待的滋味不好受,更有甚者传达错误,等来的是一堆废纸;而另一些同行会给老师提供一个选择的机会,加钱升级成合作项目,美其名曰合作共赢。
而开泰始终坚持以客户为本,让客户花的每一分钱都物超所值,在不额外收费的基础上,让老师与高级生信分析人员面对面交流分析需求、结果解读、文章思路等,享受合作文章客户的待遇,快速、高效、准确完成数据到文章的转化!一起来看项目日常推进沟通:

2024年4月12日正式步入高级分析,建立高级分析沟通群,拉入销售经理(与老师面对面协调),销售总监(负责协调资源),高级生信分析(负责技术沟通与具体分析),高级技术支持(负责协调沟通)。第一关--细胞注释!








经过一个月的通力合作,项目数据从杂乱无章到头头是道;生物学故事从无从说起,到咋说咋有理,这就是单细胞的魅力,这也是沟通的魅力!两位老师的沟通未完待续,不过可以肯定的是,这篇文章发表指日可待!
产品优势
开泰生物长期专注于高通量单细胞多组学的技术研发与服务,单细胞悬液制备经验丰富,可根据物种及组织部位提供定制化解决方案,稳定高效的完成大多数组织样本的单细胞解离,保证单细胞数据产出,结合成熟的生信分析,流畅的沟通平台,为单细胞科研保驾护航!
解离经验
开泰依靠强大的实验研发团队,成功解离了上百例组织样品,拥有丰富的单细胞解离经验,在最难的植物单细胞原生质体制备方面,也小有建树。随着春去夏来,我们制备过原生质体的植物组织已经远不止下图中展示的这些,但是还是想给你看看这张旭日东升图,就像植物单细胞技术,正冉冉升起!

同样想给你看的的还有我们的单细胞(核)悬液质检图,每一幅质检图都是我们骄傲的足迹。
欢迎各位老师垂询,每位老师都有机会获得样本的免费解离测试机会哦~

全链条产品搭配,一站式科研服务
最后再放我们的产品一览图,主打全链条产品搭配,一站式科研服务!

联系我们



English

